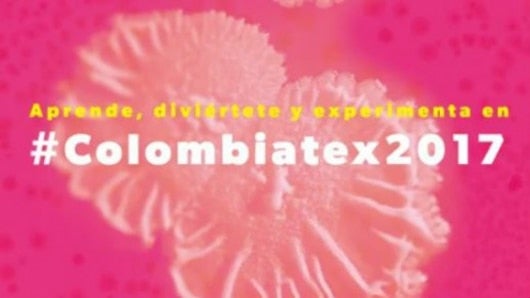
Foto: @inexmoda (Facebook).

Terminó la edición 29 de Colombiatex de las Américas
La gerente de Prendas de Vestir de ProColombia, Catalina Hernández, afirmó que Colombia demostró de nuevo ser "muy fuerte" en nichos de mercado con alta tecnología.
Noticias RCN
06:23 p. m.
Colombiatex de las Américas, la feria de negocios del sector textil más importante de América Latina, cerró este jueves con expectativas de negocios por 326 millones de dólares, un 4 % más que en 2016, dijeron los organizadores.
El evento también congregó a 21.924 visitantes entre compradores, expositores y medios de comunicación, un 5,5 % más que en el año anterior.
En total participaron más de 14.00 compradores, el 14 % de ellos de procedencia internacional, venidos de 43 países, muchos de los cuales participaron en la Rueda de Negocios organizada por ProColombia, la entidad del Gobierno colombiano que promueve el turismo, la inversión extranjera, las exportaciones mineroenergéticas, la marca país y la alcaldía de Medellín.
Los principales países compradores fueron Estados unidos, Ecuador, México y Perú, mientras que los países que más expositores aportaron al evento fueron Colombia (58 %), India (8 %), Brasil (8 %), España (6 %) e Italia (5 %).
En la rueda de prensa de presentación de resultados de Colombiatex 2017, el presidente ejecutivo de Inexmoda, Carlos Eduardo Botero, afirmó que durante la feria se palpó un "muy buen ambiente" en el sector y aseguró que observó una dinámica "muy positiva" entre los expositores y compradores.
"Es muy importante continuar con el tema exportador y buscar nuevos mercados de nicho con valor agregado. No podemos ceder en ese campo para lograr complementar el mercado local y el exterior", apostilló.
A su vez, la gerente de Prendas de Vestir de ProColombia, Catalina Hernández, afirmó que Colombia demostró de nuevo ser "muy fuerte" en nichos de mercado con alta tecnología y destacó que el país es considerado un "proveedor fiable" en los mercados internacionales.
"En términos de turismo esta feria es un éxito", aseguró por su parte la secretaria de Desarrollo Económico de Medellín, María Fernanda Galeano.
La funcionaria confirmó que se cumplieron los objetivos del gobierno de Medellín a nivel de impacto económico en la ciudad y anunció que durante la feria la ocupación hotelera en la ciudad se acercó al 100 %.
A la par de la exhibición y los encuentros de negocios, Colombiatex ofreció, en alianza con la Universidad Pontificia Bolivariana (UPB), conferencias dirigidas a los profesionales del sector que asistieron a la feria.
En total, Colombiatex acogió en su XXIX edición 36 conferencias y talleres en los que participaron 8.229 asistentes (un 19 % más) que han debatido sobre las nuevas tendencias y perspectivas del sector.
"Buscamos ser un espacio de actualización tanto para estudiantes, como para diseñadores, comunicadores y empresarios. Es un punto de formación, cualificación y refrescamiento de conocimientos", explicó a Efe la coordinadora de la alianza entre Inexmoda y la Universidad Pontificia Bolivariana (UPB), Amparo Velásquez.
EFE





